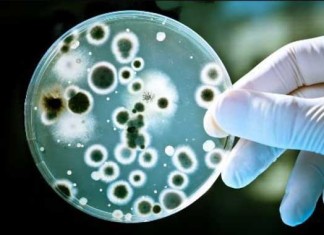

El estrés crónico conduce a la inflamación del cerebro y pérdida...
Las personas que experimentan estrés crónico debido a la intimidación o un trabajo duro, y porque no decir estresante, también corren un mayor riesgo...
Los efectos de envejecer: ¿podemos revertirlos?
Las arrugas, el pelo gris, pobre salud física y cognitiva: estas son algunas de las manifestaciones comunes del envejecimiento. Pero, ¿podría ser posible revertir...
Bacteria de la enfermedad de encías relacionada con el cáncer de...
En un nuevo estudio, los investigadores proponen por primera vez que Porphyromonas gingivalis - la bacteria causante de la enfermedad de las encías -...
El consumo de cannabis afecta el procesamiento de las emociones
El cannabis parece tener un impacto significativo en el reconocimiento y el procesamiento de las emociones humanas, tales como la felicidad, la tristeza y...
Las drogas y la verdad sobre los máximos legales
En los últimos años, cientos de nuevas y recreativas "drogas de diseño" sintéticas han aparecido en el mercado - un mercado con un vacío legal que...
Diabetes tipo 2: medicamentos para la presión arterial pueden ser perjudiciales
Para algunos pacientes con diabetes tipo 2, el tratamiento con medicamentos para bajar la presión arterial de la sangre puede ser más perjudicial que beneficioso....
Cúrcuma: Beneficios para la salud e información nutricional
La cúrcuma es una planta perenne herbácea de la familia del jengibre, nativa de suroeste de la India. La cúrcuma se consume comúnmente en...
El cáncer de páncreas identificado como cuatro enfermedades separadas
Después de llevar a cabo un análisis detallado de la interrupción genética del ADN, la expresión de genes y vías moleculares en cientos de...
¿Hay que suavizar nuestro enfoque a la mutilación genital femenina?
Un artículo publicado esta semana en la revista Journal of Medical Ethics pregunta si algunas formas de mutilación genital femenina deberían ser legalizados en...
¿Qué es y cuáles son los ejercicios de Kegel?
Los ejercicios de Kegel, también conocidos como ejercicios del suelo pélvico o simplemente Kegel, son ejercicios especiales que se destinan a fortalecer los músculos pélvicos...
Inflamación de la vesícula biliar: Sintomas, Cuidados y Complicaciones
La vesícula biliar es un órgano en el sistema digestivo en forma de pera, ubicado en el lado derecho del abdomen. Su función es...
¿Quieres trabajar como médico o enfermera/o en Alemania o Suiza?
Si eres médico o enfermera y tienes el deseo de trabajar en el sector de la salud en Alemania o Suiza como médico, asistente médico,...